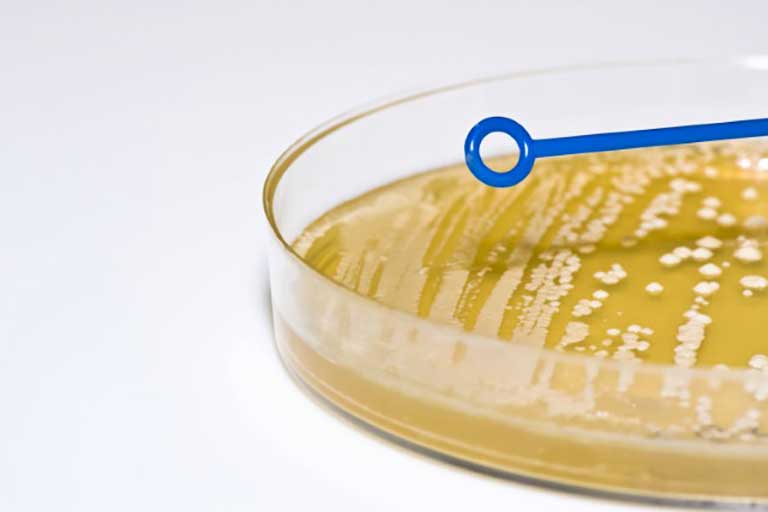

Microbiology
Eurofins offer high quality, reliable microbiological analysis and competent advice from our experts. We help companies in the food and beverage, biotechnology, health supplement, pharmaceutical as well as animal feed industries. We perform product analysis and quality control testing in accordance with local and overseas regulatory requirements. This helps our customers to prevent microbiological contamination of their products and in their food processing environments.
Eurofins Food Testing Singapore’s microbiology laboratory is accredited to ISO/IEC 17025:2017 General requirements for the competence of testing and calibration laboratories by the Singapore Laboratory Accreditation Scheme (SAC-SINGLAS). We are also recognised by the Singapore Food Agency (SFA) under the Laboratory Recognition Programme (LRP).
Our microbiology laboratory is using an extensive selection of industry-standard methods, including FDA BAM, AOAC, ISO and USP methods. Eurofins offers microbiological testing for a wide range of matrices in some of the following food and product groups:
- Food
- Animal feed
- Cosmetics
- Food ingredients/additives
- Medicines
- Health Supplements
Eurofins Microbiology laboratories offer a wide scope of tests that include the following:
Typical enumeration tests:
- Aerobic & Anaerobic Plate Count
- Acid Producing Bacteria & Lactic Acid Bacteria
- Bacillus cereus
- Total Coliforms, Faecal Coliforms & E.coli
- Clostridium perfringens
- Enterobacteriaceae
- Pseudomonas species
- Staphylococcus aureus
- Sulphite Reducing Bacteria
- Yeast and Moulds
Pathogens and detection tests:
- Campylobacter species
- Listeria monocytogenes
- Salmonella
- Shigella
- Vibrio species